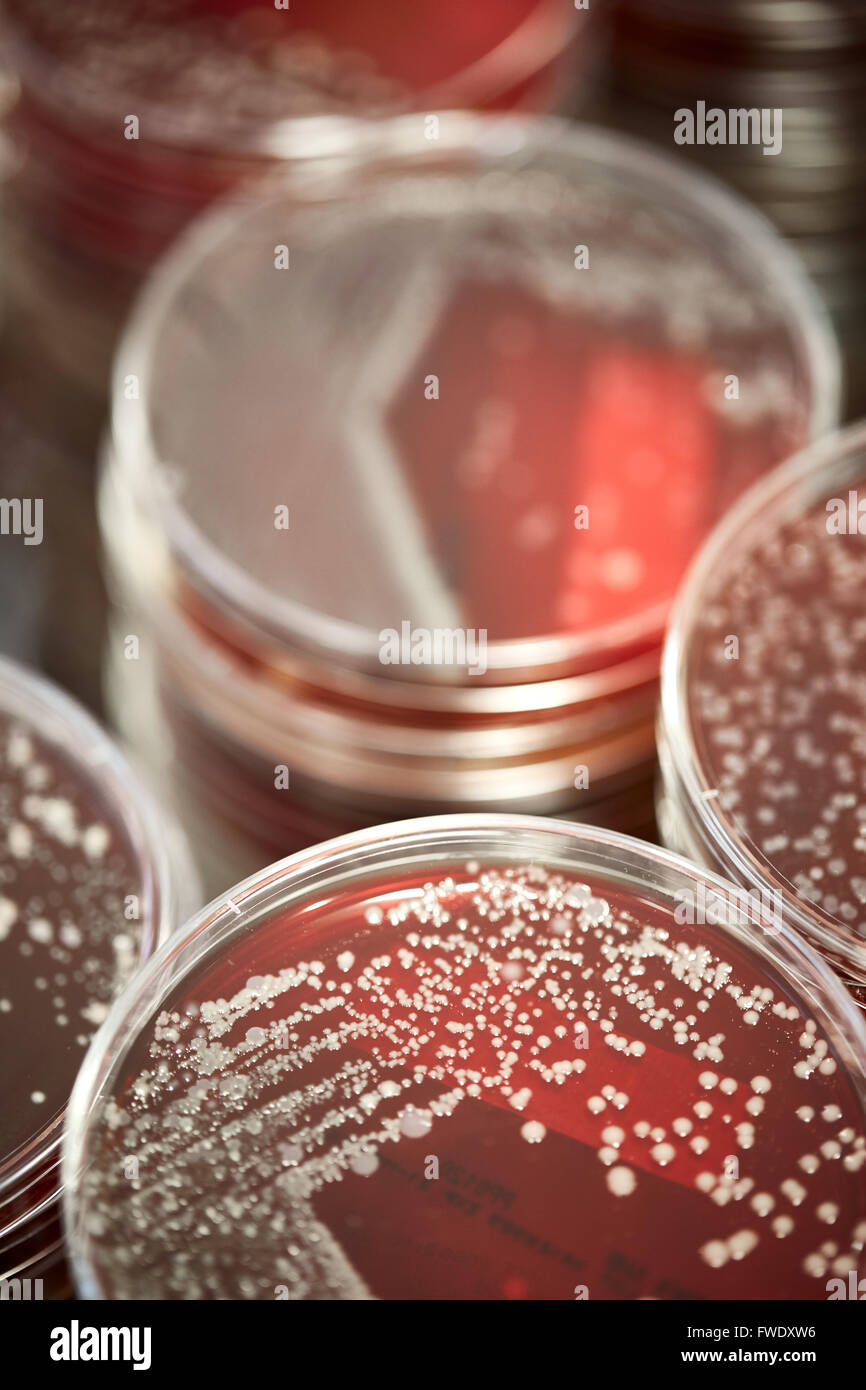
Piastre di sangue antibiotici test di campioni liquidi lab laboratorio prove di laboratorio prove di analisi del paziente analizzato il siero bl Foto Stock

Piastre di sangue antibiotici test di campioni liquidi lab laboratorio prove di laboratorio prove di analisi del paziente analizzato il siero bl
RMID:ID dell’immagine:FWDXW6
Detagli dell'immagine
Collaboratore:
Mark WaughID dell’immagine:
FWDXW6Dimensioni dei file:
63,3 MB (1,5 MB Download compresso)Liberatorie:
Modello - no | Proprietà - noMi occorre una liberatoria?Dimensioni:
3840 x 5760 px | 32,5 x 48,8 cm | 12,8 x 19,2 inches | 300dpiData acquisizione:
30 marzo 2016Altre informazioni: